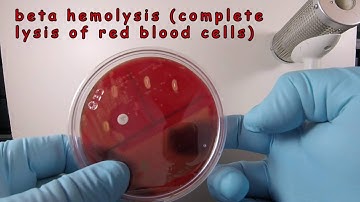
Streptococcus pyogenes on Blood Agar with a Taxo A Disc

⬇ DOWNLOAD NOW
Kalau muncul iklan pop-up, tutup lalu klik tombol kembali
Download lagu Streptococcus pyogenes secara gratis hanya untuk keperluan promosi. Dukung artis favorit kamu dengan membeli musik original di iTunes atau platform resmi lainnya.
 Streptococcus pyogenes (Group A Strep) - causes, symptoms, diagnosis, treatment, pathology
Streptococcus pyogenes (Group A Strep) - causes, symptoms, diagnosis, treatment, pathology
 Streptococcus Pyogenes
Streptococcus Pyogenes
 Streptococcus pyogenes: Infection Fundamentals | USMLE Step 1 | Sketchy Medical
Streptococcus pyogenes: Infection Fundamentals | USMLE Step 1 | Sketchy Medical
 Microbiology - Streptococcus species
Microbiology - Streptococcus species
 Streptococcus Pyogenes Video
Streptococcus Pyogenes Video
Streptococcus pyogenes on Blood Agar with a Taxo A Disc
Streptococcus pyogenes on Blood Agar with a Taxo A Disc
 Streptococcus pyogenes | Streptococcal infection | Structure, pathology and treatment options |usmle
Streptococcus pyogenes | Streptococcal infection | Structure, pathology and treatment options |usmle
 Streptococcus Pyogenes for the USMLE Step 1
Streptococcus Pyogenes for the USMLE Step 1